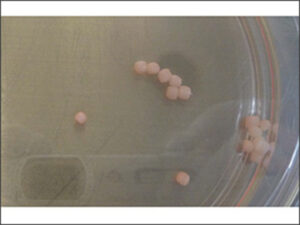
Gas-permeable ability of disposable culture vessels

- Life Science
 3D Rotational Floating Culture Device
3D Rotational Floating Culture Device
CellPet 3D-iPS
Effortless Spheroid Formation for iPS/ES Cells
Supporting Highly Reproducible Cultures
※Image after culture and immunostaining
Proprietary 3D rotational floating culture technology applicable to spheroid formation and differentiation induction
CellPet 3D-iPS is a 3D rotational floating culture device adopting proprietary CELLFLOAT technology for spheroid and organoid cultivation of iPS cells. Its closed-system culture vessel reduces contamination risk and reproducibly forms uniformly-sized spheroids.
Product Features

- Realizes a culture environment with gentle flow generated by slow rotation
- Obtain spheroids with uniform particle size and easily perform 3D culture
- Reduces contamination risk with externally sealed culture vessel
- Disposable culture vessel using gas-permeable resin
Examples of culture results
- iPS cells
- ES cells
- Differentiated cells derived from iPS cells
- Human-derived cancer cells
Growth images of iPS cell spheroids

Related papers
J. Takahashi et al., “Controlled aggregative assembly to form self-organizing macroscopic human intestine from induced pluripotent stem cells”, Cell Rep. Methods, vol. 4, no. 12, p. 100930, Dec. 2024.
http://doi.org/10.1016/j.crmeth.2024.100930
J. Takahashi et al., “Protocol to generate large human intestinal organoids using a rotating bioreactor”, STAR Protoc., vol. 4, no. 3, p. 102374, Sep. 2023.
https://doi.org/10.1016/j.xpro.2023.102374
J. Takahashi et al., “Suspension culture in a rotating bioreactor for efficient generation of human intestinal organoids”, Cell Rep. Methods, vol. 2, no. 11, p. 100337, Nov. 2022.
http://doi.org/10.1016/j.crmeth.2022.100337
Our Proprietary Technology ”3D Rotational Floating Culture Technology “CELLFLOAT”


What is CELLFLOAT?
CELLFLOAT is our proprietary 3D rotational floating culture technology.
This is a method of culturing cells (spheroids) in a floating state (non-adhesive) by balancing the buoyancy and gravitational force that the cells (spheroids) receive from the flow generated by constantly rotating the cylindrical culture vessel. Stable culture results can be expected due to moderate shear stress from the constant gentle flow, removal of waste products produced by the cells themselves such as lactic acid, and proper nutrient absorption from the culture medium.
Application Notes
Analysis of Exosome Secretion from Human Mesenchymal Stromal Cell Spheroids
We generated adipose-derived human mesenchymal stromal cell spheroids (hMSC-AdpS) with uniform particle size using CellPet 3D-iPS. After enzymatic dissociation of the hMSC-AdpS and subsequent static culture in exosome production medium, exosome yield was approximately 1.3 times higher compared to the control.
Chondrogenic differentiation from hMSC spheroids
We generated spheroids of human mesenchymal stromal cells using CellPet 3D-iPS and induced chondrogenic differentiation by switching the culture medium. Compared to chondrogenic differentiation in monolayer culture, the spheroids produced greater amounts of hyaluronic acid and elastic fibers. Additionally, cartilage lumen, a characteristic feature of mature cartilage tissue, were observed within the tissue.
Gas permeability evaluation of disposable culture vessels
We evaluated the gas permeability of the disposable vessel of CellPet 3D-iPS. After removing oxygen and carbon dioxide from the culture medium by nitrogen bubbling, the extent to which each gas permeated the vessel and dissolved into the culture medium was examined. After about one hour, the concentration of dissolved oxygen in the vessels reached the same level as that in the culture dish.
hMSC spheroid culture using CellPet 3D-iPS
We performed spheroid culture of human mesenchymal stromal cells using CellPet 3D-iPS. The cells were seeded into a culture vessel, and the medium was replaced every three days. On day six, the spheroids were enzymatically dissociated into single cells, and the cells were divided into two equal parts, which were then seeded into two separate culture vessels to continue the culture. Over the 12-day culture period, we observed an approximately eight-fold increase in cell proliferation. The diameter distribution of the obtained spheroids was uniform, and it was confirmed that the characteristics of mesenchymal stromal cells were maintained.
iPS trilineage differentiation using CellPet 3D-iPS
We performed 3D rotary floating cultures of iPS cells using CellPet 3D-iPS. When using APEL2 medium, an increase in the expression of the trilineage differentiation markers Sox1, PDGFRα, and Sox17 was observed. This suggests that spheroid cultures using APEL2 medium and CellPet 3D-iPS can induce differentiation.
Gas-permeable ability of disposable culture vessels
We performed spheroid cultures of iPS cells and osteosarcoma cells using both a newly developed disposable culture vessel and a conventional glass culture vessel. The disposable vessel, which has excellent gas permeability, was able to maintain a high dissolved oxygen concentration during spheroid culture. Additionally, the use of the disposable vessel enabled the formation of spheroids in osteosarcoma cells, which was not possible with the glass vessel.
iPS spheroid culture using CellPet 3D-iPS
We performed spheroid culture of iPS cells using CellPet 3D-iPS. Upon evaluating the size distribution of the spheroids on day 4 of culture, approximately 60% had a diameter of 200-300 μm, indicating the formation of uniform iPS spheroids. It was also confirmed that the expression of undifferentiated markers was maintained during culture with CellPet 3D-iPS.
Product Specifications
CellPet 3D-iPS
| Model | CELLPET iPS/3S/MA-2.1 |
|---|---|
| Rotation speed range | 5 – 50 rpm |
| Size | Width 176 mm × Depth 176 mm × Hight 100 mm |
| Weight | 3.3 kg |
| Ambient temperature | 15 – 40 degrees Celsius (Usable in CO2 incubator) |
| Ambient humidity | Relative humidity 30 – 95% (Usable in CO2 incubator) |
Controller for CellPet 3D-iPS
| Model | CELLPET iPS/CO3-2.1 |
|---|---|
| Number of CellPet 3D-iPS units connected | Max. 3 units |
| Display Monitor | 6.5 inch touch panel LCD |
| Size | Width 200 mm × Depth 303 mm × Hight 151.8 mm |
| Weight | 4.3 kg (Excluding cables) |
| Input power | AC 100 V 0.2 A |
| Ambient temperature | 15 – 30 degrees Celsius |
| Ambient humidity | Relative humidity 30 – 80% |
Controller for CellPet 3D-iPS for Academic
| Model | CELLFLOAT/CO1 |
|---|---|
| Number of CellPet 3D-iPS units connected | Max. 1 unit |
| Size | Width 98 mm × Depth 230 mm × Hight 137.5 mm |
| Weight | 1.5 kg |
| Input power | AC 100~240 V 0.1 A |
| Ambient temperature | 15 – 30 degrees Celsius |
| Ambient humidity | Relative humidity 30 – 80% |
■CellPet 3D-iPS is for research use only.
Consumables
| Product Name | Specifications | Quantity per pack | Product Code |
|---|---|---|---|
| Disposable culture vessel | Volume: 10 mL | 6 vessels | CELLPET VES/S10/6 |
| Volume: 30 mL | 6 vessels | CELLPET VES/S30/6 | |
| Volume: 50 mL | 6 vessels | CELLPET VES/S50/6 |
■These Consumables are for research use only.